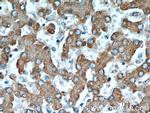
RWDD3 Antibody in Immunohistochemistry (Paraffin) (IHC (P))

Search
Proteintech
RWDD3 Polyclonal Antibody
{{$productOrderCtrl.translations['antibody.pdp.commerceCard.promotion.promotions']}}
{{$productOrderCtrl.translations['antibody.pdp.commerceCard.promotion.viewpromo']}}
{{$productOrderCtrl.translations['antibody.pdp.commerceCard.promotion.promocode']}}: {{promo.promoCode}} {{promo.promoTitle}} {{promo.promoDescription}}. {{$productOrderCtrl.translations['antibody.pdp.commerceCard.promotion.learnmore']}}
产品信息
22737-1-AP
种属反应
宿主/亚型
分类
类型
抗原
偶联物
形式
浓度
规格
纯化类型
保存液
内含物
保存条件
运输条件
产品详细信息
Immunogen sequence: MFLSCGSLH QRGPETDGTV FRIHTKAEGF MDADIPLELV FHLPVNYPSC LPGISINSEQ LTRAQCVTVK EKLLEQAESL LSEPMVHELV LWIQQNLRHI LSQPETGSGS EKCTFSTSTT MDDGLWITLL HLDHMRAKTK YVKIVEKWAS DLRLTGRLMF MGVLDSSENL QSRCGLKWKE MQREND (1-185 aa encoded by B C125142)
靶标信息
RWDD3 (RSUME), a small RWD-containing protein, has a central role in sumoylation by enhancing SUMO conjugation in the regulatory network of immune-inflammatory signals. RWDD3 increases Ikappa-Beta sumoylation and stability. In addition, RWDD3 inhibits TNF-a-induced kappaB-LUC (Luciferase) reporter activity, showing the functional consequence of Ikappa-Beta increased stability. RSUME-enhanced sumoylation of Ikappa-Beta leads to the inhibition of NF-kappa-Beta activity on two well-known inflammatory genes, IL-8 and cyclooxygenase-2 (Cox-2) and therefore may also favor anti-inflammatory pathways. Expression of RWDD3 was induced under hypoxic conditions and it has a potential role during vascularization. Both BMP-4 and RWDD3 may be interesting targets for inhibiting steps involved in pituitary tumorigenesis.
仅用于科研。不用于诊断过程。未经明确授权不得转售。
篇参考文献 (0)
生物信息学
蛋白别名: RSUME; RWD domain-containing protein 3; RWD domain-containing sumoylation enhancer; RWD-containing sumoylation enhancer; RWDD3; unnamed protein product
基因别名: RSUME; RWDD3
UniProt ID: (Human) Q9Y3V2
Entrez Gene ID: (Human) 25950